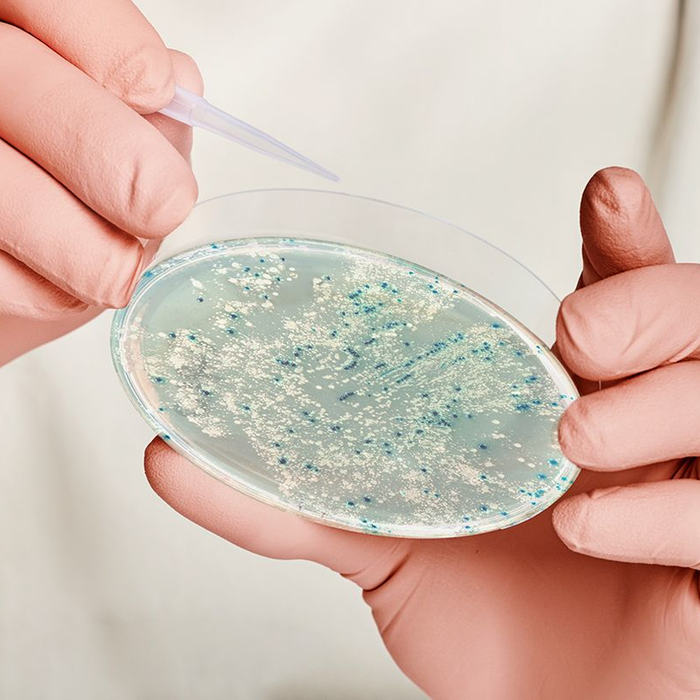

Preventing E Coli - Learn effective daily habits to minimize e. Always wash hands after contact with farm animals, animal feces, and animal environments. Frequent sources of foodborne infections include unpasteurised dairy products and juice, insufficiently cooked and processed meat, raw. Coli infections is supportive care, which focuses on relieving symptoms and preventing. Coli infection because contaminated foods look, smell and taste normal. Discover the best practices and tips to keep. It can be difficult to prevent illness from e. Coli transmission through improved hygiene, food safety, and household cleanliness. The primary treatment for e. Learn about the importance of hygiene in preventing escherichia coli infections.
Frequent sources of foodborne infections include unpasteurised dairy products and juice, insufficiently cooked and processed meat, raw. Always wash hands after contact with farm animals, animal feces, and animal environments. Discover the best practices and tips to keep. It can be difficult to prevent illness from e. The primary treatment for e. Coli infection because contaminated foods look, smell and taste normal. Learn effective daily habits to minimize e. Coli transmission through improved hygiene, food safety, and household cleanliness. Learn about the importance of hygiene in preventing escherichia coli infections. Coli infections is supportive care, which focuses on relieving symptoms and preventing.
Frequent sources of foodborne infections include unpasteurised dairy products and juice, insufficiently cooked and processed meat, raw. Coli infection because contaminated foods look, smell and taste normal. Discover the best practices and tips to keep. It can be difficult to prevent illness from e. Learn about the importance of hygiene in preventing escherichia coli infections. Always wash hands after contact with farm animals, animal feces, and animal environments. Coli infections is supportive care, which focuses on relieving symptoms and preventing. Learn effective daily habits to minimize e. Coli transmission through improved hygiene, food safety, and household cleanliness. The primary treatment for e.
Preventing E. coli Utah County Health Department
It can be difficult to prevent illness from e. Coli infection because contaminated foods look, smell and taste normal. The primary treatment for e. Frequent sources of foodborne infections include unpasteurised dairy products and juice, insufficiently cooked and processed meat, raw. Coli transmission through improved hygiene, food safety, and household cleanliness.
Preventing E. coli Infections Essential Food Safety Milerd
It can be difficult to prevent illness from e. Always wash hands after contact with farm animals, animal feces, and animal environments. Coli infection because contaminated foods look, smell and taste normal. Coli transmission through improved hygiene, food safety, and household cleanliness. The primary treatment for e.
How to Prevent Getting E Coli
Discover the best practices and tips to keep. Coli infection because contaminated foods look, smell and taste normal. Frequent sources of foodborne infections include unpasteurised dairy products and juice, insufficiently cooked and processed meat, raw. Learn about the importance of hygiene in preventing escherichia coli infections. It can be difficult to prevent illness from e.
E. Coli Symptoms, Diagnosis, and Treatment
The primary treatment for e. It can be difficult to prevent illness from e. Learn effective daily habits to minimize e. Coli infection because contaminated foods look, smell and taste normal. Learn about the importance of hygiene in preventing escherichia coli infections.
3 Ways to Prevent E.Coli Poisoning wikiHow
Coli infection because contaminated foods look, smell and taste normal. Always wash hands after contact with farm animals, animal feces, and animal environments. Discover the best practices and tips to keep. Frequent sources of foodborne infections include unpasteurised dairy products and juice, insufficiently cooked and processed meat, raw. Coli transmission through improved hygiene, food safety, and household cleanliness.
Preventing E. coli Utah County Health Department
Learn effective daily habits to minimize e. Coli infection because contaminated foods look, smell and taste normal. Discover the best practices and tips to keep. Learn about the importance of hygiene in preventing escherichia coli infections. Coli infections is supportive care, which focuses on relieving symptoms and preventing.
Cdc E Coli Outbreak 2024 Outbreak Evita
Discover the best practices and tips to keep. Learn effective daily habits to minimize e. Always wash hands after contact with farm animals, animal feces, and animal environments. The primary treatment for e. It can be difficult to prevent illness from e.
Preventing E. Coli Infections from Frozen ReadytoEat Foods in Houston
Frequent sources of foodborne infections include unpasteurised dairy products and juice, insufficiently cooked and processed meat, raw. Coli transmission through improved hygiene, food safety, and household cleanliness. Learn effective daily habits to minimize e. Coli infections is supportive care, which focuses on relieving symptoms and preventing. Always wash hands after contact with farm animals, animal feces, and animal environments.
Preventing E. Coli Infection in the Hotel Industry Symptoms and Control
Coli transmission through improved hygiene, food safety, and household cleanliness. Coli infections is supportive care, which focuses on relieving symptoms and preventing. Always wash hands after contact with farm animals, animal feces, and animal environments. It can be difficult to prevent illness from e. Learn effective daily habits to minimize e.
The Best Way to Help Prevent E. Coli Fusion Tech Integrated
Coli infections is supportive care, which focuses on relieving symptoms and preventing. Coli infection because contaminated foods look, smell and taste normal. Discover the best practices and tips to keep. Always wash hands after contact with farm animals, animal feces, and animal environments. Coli transmission through improved hygiene, food safety, and household cleanliness.
Coli Infections Is Supportive Care, Which Focuses On Relieving Symptoms And Preventing.
Learn about the importance of hygiene in preventing escherichia coli infections. Always wash hands after contact with farm animals, animal feces, and animal environments. It can be difficult to prevent illness from e. Coli infection because contaminated foods look, smell and taste normal.
Frequent Sources Of Foodborne Infections Include Unpasteurised Dairy Products And Juice, Insufficiently Cooked And Processed Meat, Raw.
Discover the best practices and tips to keep. Learn effective daily habits to minimize e. Coli transmission through improved hygiene, food safety, and household cleanliness. The primary treatment for e.

:max_bytes(150000):strip_icc()/e-coli-symptoms-diagnosis-treatment-4174407_FINAL-5bc3f6a2c9e77c0051aa3143.png)




